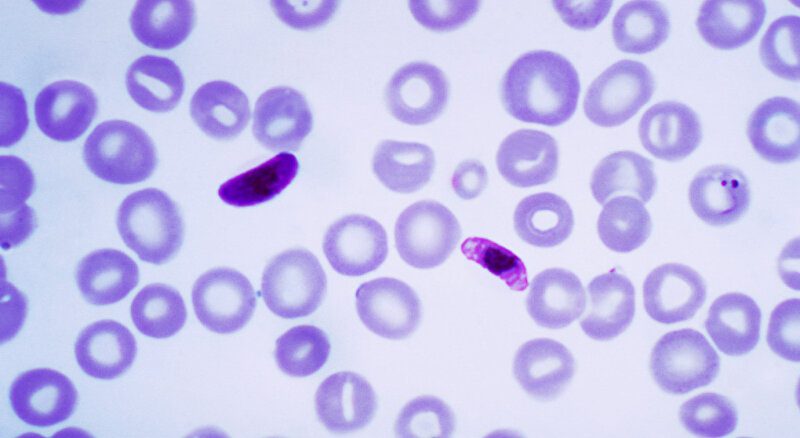

Almanya merkezli biyoteknoloji firması BioNTech dünya çapında ilk onay alan Covid-19 aşısını geliştirmek için kullandığı mRNA teknolojisini sıtma aşısı üretmek için kullanmayı hedefliyor. Firmanın sahibi Prof. Dr. Uğur Şahin önümüzdeki yılın sonuna kadar güvenli ve etkili bir sıtma aşısı geliştirmek için klinik deneylere başlama amacında olduklarını açıkladı.
Almanya merkezli biyoteknoloji firması BioNTech dünya çapında ilk onay alan Kovid-19 aşısını geliştirmek için kullandığı mRNA teknolojisini sıtma aşısı üretmek için kullanmayı hedefliyor.
Firmanın sahibi Prof. Dr. Uğur Şahin önümüzdeki yılın sonuna kadar güvenli ve etkili bir sıtma aşısı geliştirmek için klinik deneylere başlama amacında olduklarını açıkladı.
- Tıbbi olarak çözüm bulunamayan üç hastalıktan AIDS/HIV ve vereme karşı çalışmalarını sürdürdüklerini belirten Şahin sıtmanın her yıl inanılamayacak düzeyde insana bulaştığına, sıtma nedeniyle çok yüksek sayıda hastanın hayatını kaybettiğine ve bu ağır hastalığın özellikle küçük çocuklarda yüksek oranda ölüme yol açtığına dikkat çekti.
Bu işin garantisi yok
Prof. Şahin, sıtma aşısıyla ilgili çalışmalarının başlangıç aşamasında olduğunu ve başarı için bir garantinin bulunmadığının altını çizdi. Ancak koronavirüse karşı aşı geliştirirken mRNA teknolojisine daha hakim olduklarını ve bu arada sıtmayla ilgili de daha geniş bilgi edindiklerini belirten Şahin, firma olarak bu konuyla mücadele etmek için mükemmel zaman olduğuna inandıklarını kaydetti.
- Ancak uzmanlar sıtmaya karşı vücutta bağışıklık geliştirilmesinin zor olabileceğine dikkat çekiyor.
John Hopkins Üniversitesi Bloomberg Halk Sağlığı bölümümden Doç. Dr. Prakash Srinivasan, ilaç firması GlaxoSmithKline tarafından geliştirilen ve üç Afrika ülkesinde denemeleri devam eden sıtma aşısının güçlü ve uzun süreli antikor üretmede zorlandığını belirtti.
Virüsten daha karmaşık
Sıtmaya yol açan Plasmodium parazitinin gen diziliminin virüsten daha karmaşık olduğunun altını çizen Srinivasan ayrıca parazitin varolan ve gelecekteki varyantlarının da etkin aşı geliştirmede güçlüğe neden olabileceğini kaydetti.